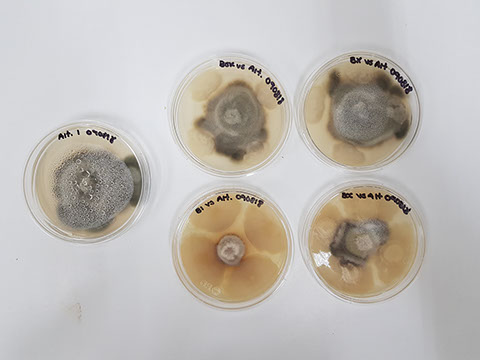
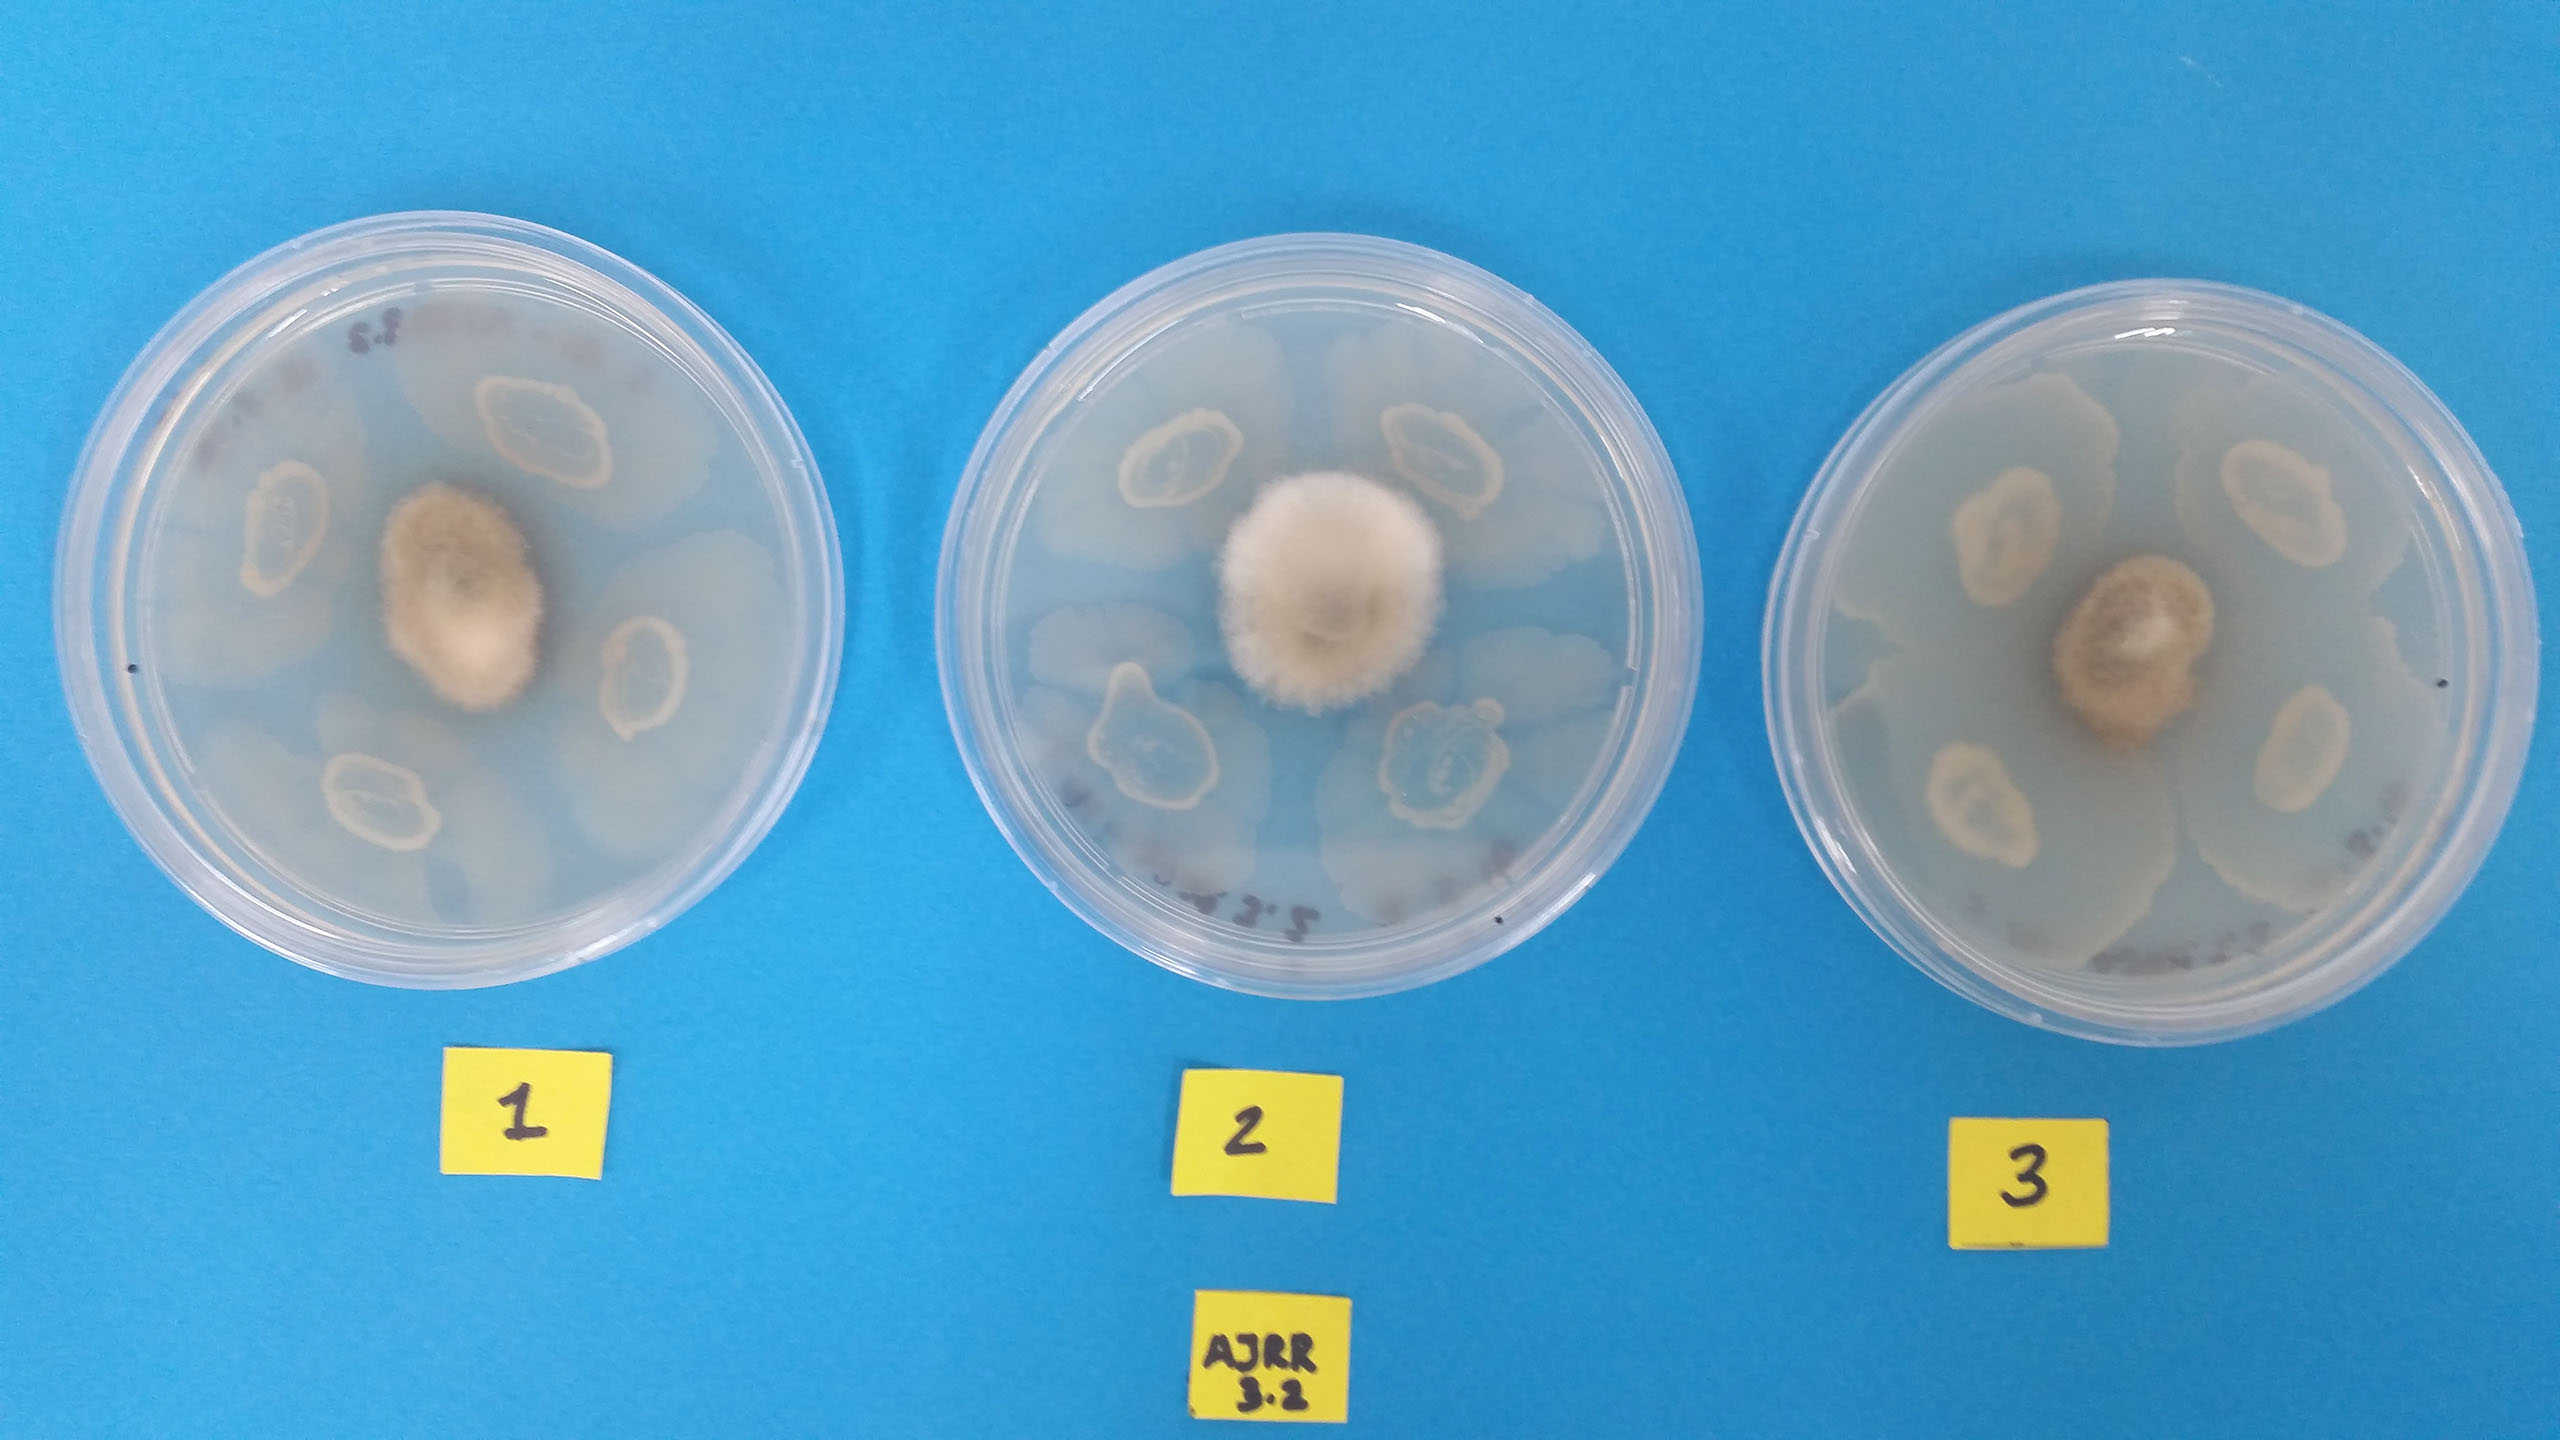

LABORATORIO ZUSTATEK
Inicio > Desarrollo
Laboratorio Zustatek • BioStar México
\\\\\\\\\\\\\\\\\\\\\\\\\\\\\\\\\\\\\\\\\\\\\\\\\\\\\\\\\\\\\\\\\\\\\\\\\\\\\\\\\\\\\\\\\\\\\
Contamos con el respaldo de Zustatek (Laboratorio de investigación y desarrollo), en donde constantemente se analizan nuevas alternativas que ofrezcan un beneficio al Agro Mexicano, además se tienen convenios de colaboración con Universidades y Centros de Investigación para el desarrollo y evaluación de nuevos productos.

Nuestras líneas de investigación
• Bacterias esporuladas para el manejo de fitopatógenos.
• Hongos micoparásitos y antagónicos.
• Hongos y bacterias entomopatógenos.
• Biofertilizantes
- Micorrizas.
- Solubilizadoras de fósforo y potasio.
- Fijadoras de nitrógeno simbióticas y de vida libre.
- Sideróforos.
• Hongos y bacterias nematófagos.

Picudo del frijol infectado
Picudo del frijol infectado de paecilomyces
Paecilomyes en picudo del frijol
Micorriza
Gusano micosado
Gusano parasitado
Hongo entompatogeno
Micorriza ambar
Micorriza café
Antibiosis
Bioshield-R antagonismo
<
>





.jpg?crc=435648163)

BioStar México
Somos una empresa especializada en ingeniería & diseño de insumos agrícolas de bajo impacto ambiental para el control de plagas, enfermedades y nutrición vegetal enfocado en el bienestar del agricultor.
Línea de Productos
• Reguladores de Crecimiento.
• Fungicidas e Insecticidas Orgánicos.
• Fertilizantes Foliares y al Suelo.
• Mejoradores de Suelo.
• Activadores Fisiológicos.
• Acondicionadores de Agua.
• Inoculantes y Biofertilizantes
Microbiológicos.
Servicio a Clientes
Contáctanos
Tel. : +52 (844) 416 1030
contacto@biostar.mx
www.biostar.mx
Laguna del Carmen No. 1120,
Col. Fracc. La Salle,
Saltillo, Coahuila. 25240
©2018. BioStar México by R4B.MX All Rights Reserved®
